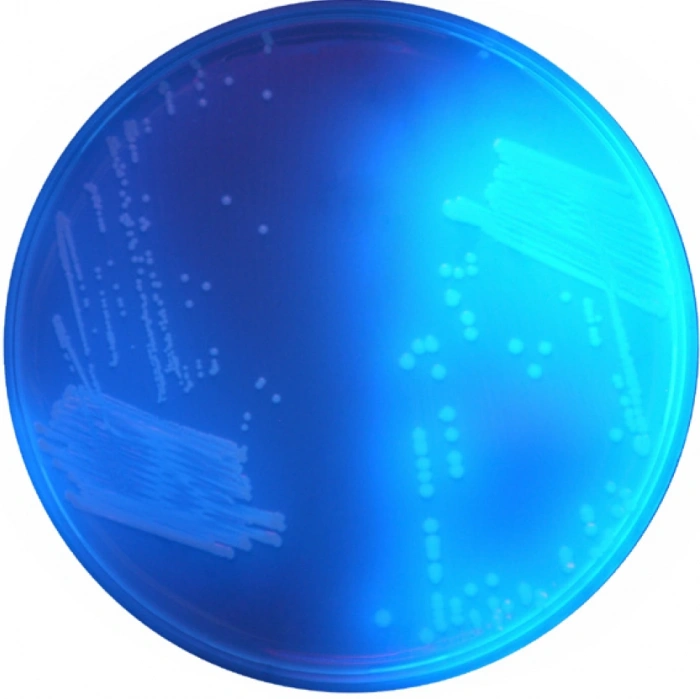
CHROMagar C.difficile 10 Adet
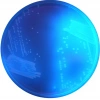
CHROMagar C.difficile 10 Adet

Tüm Kategoriler
- BESİYERİ & KİMYASALLAR
-
SARF MALZEMELER
PLASTİK MALZEMELER
- Tüp Kapakları
- Falkon Tüpler
- Plastik Petri Kutusu
- Hücre Kültürü Ürünleri
- Enjektör
- Tüp Standları
- Spatül (PP)
- Hücre Sıyırıcı
- Pipet Standı
- Pipetler
- Pipet Ucu
- Pastör Pipeti
- Beherler
- Krozeler
- Havan
- Saat Camı
- Balık ve Balık Tutucular
- Plastik Mezür
- Lam Kutusu
- Desikatör (PP)
- Buhner Hunisi
- Huni (PP)
- Plastik Tüpler
- Huni Halkası (PP)
- Micropipet
- Hücre Sıyırıcı ve Özeler
- Piset
- Erlen (PP)
- NUMUNE ALMA
- LAB. CİHAZLARI
- LAB. GÜVENLİĞİ